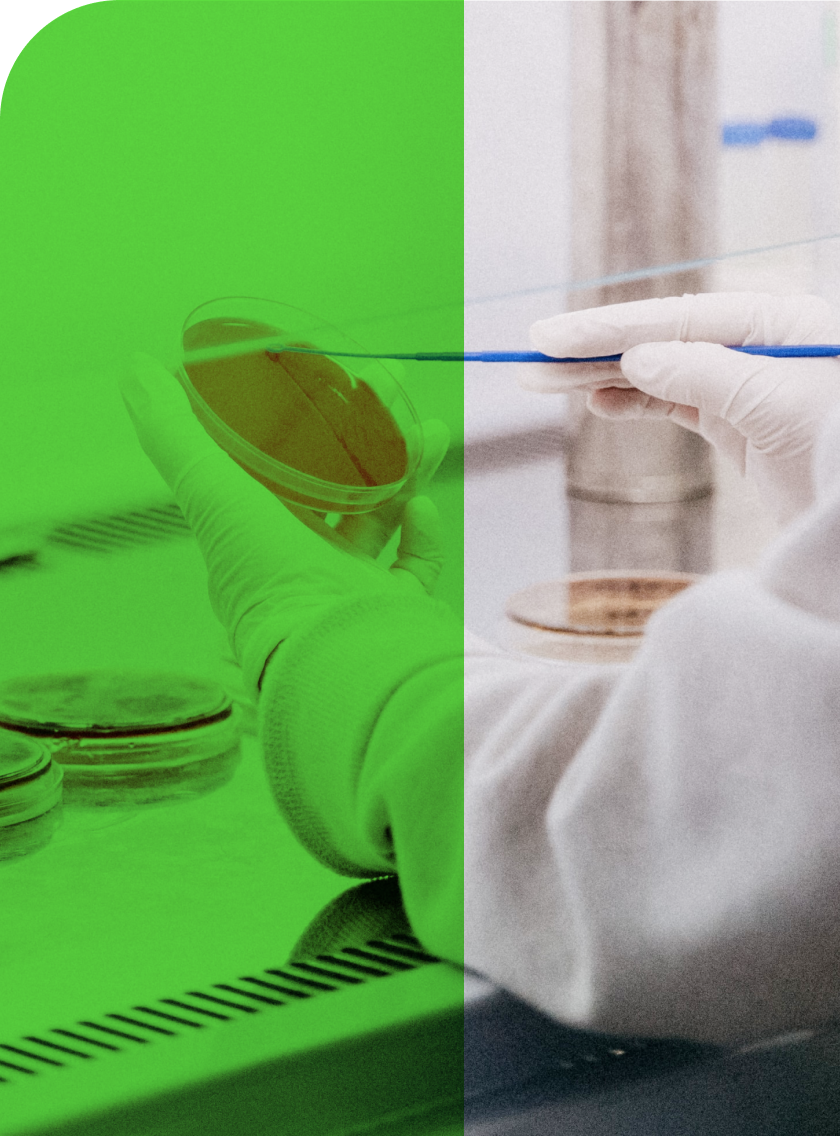

CLSI has a longstanding globally trusted reputation for its diligent development of Microbiology and Antimicrobial Susceptibility Testing (AST) standards and guidelines on test methods and QC procedures. Additionally, CLSI annually creates and revises AST breakpoints to meet global public health challenges related to antimicrobial resistance.
CLSI is a longstanding collaborating center with the United Nation’s World Health Organization (WHO), the International Organization for Standardization (ISO, and the American National Standards Institute (ANSI), as the only organization specifically designated for the creation, revision, and translation of medical laboratory standards.
CLSI is a highly respected organization that bases its standard development activities on an open and transparent consensus-based process that includes all affected stakeholders.